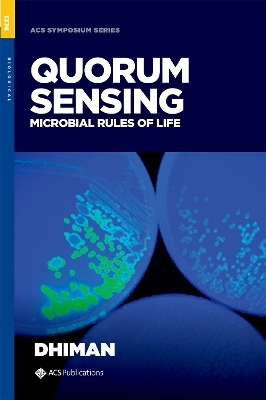
Quorum Sensing

Buch | Hardcover
2021
|
Urban & Fischer in Elsevier
ISBN: 9783437440977
CHF 299,95 (inkl. MwSt)
- Titel ist leider vergriffen;
keine Neuauflage

![Studies in the Regeneration of Denervated Mammaliam Muscle [microform]](/media/101544241)
![Atlas of the Descriptive Anatomy of the Human Body [electronic Resource]](/media/101589486)



